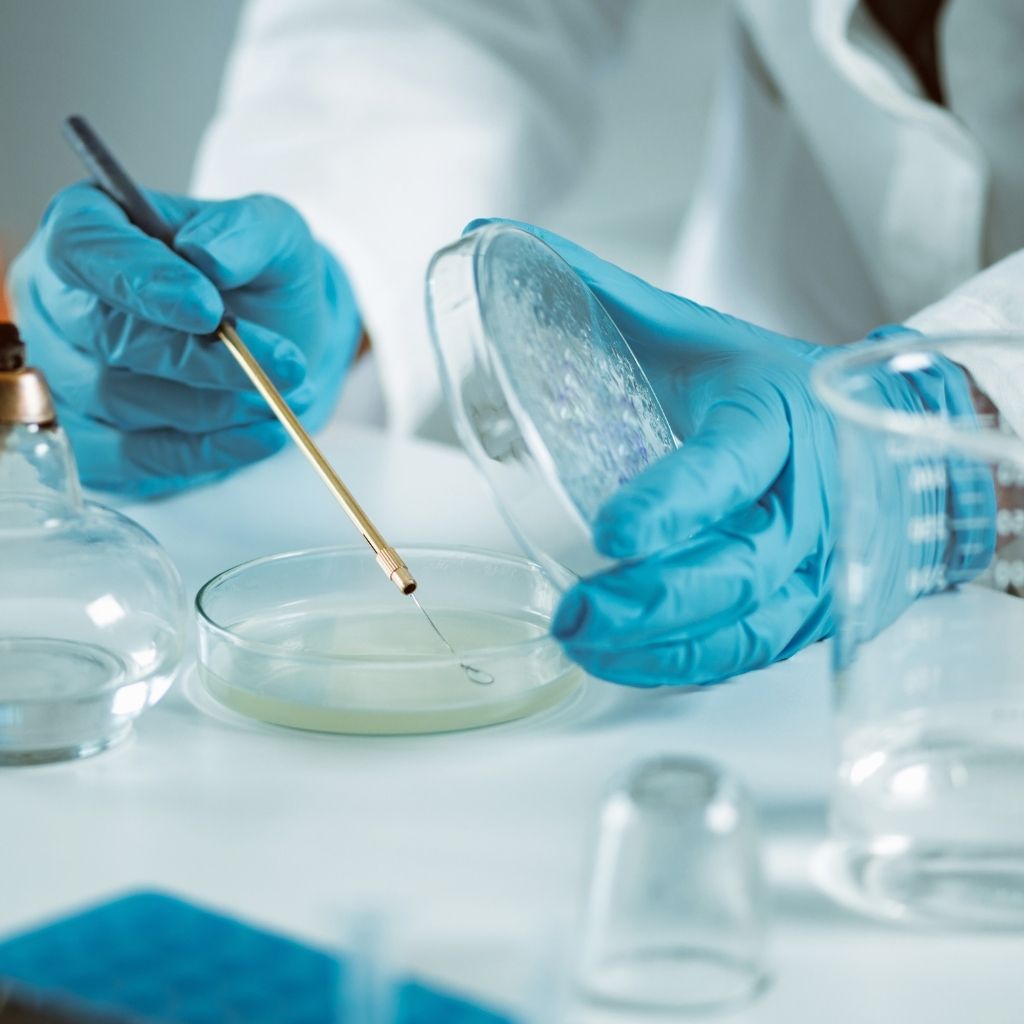
Микробиологична лаборатория

- 0670 62 022
- mbal_troyan@abv.bg
- ул. „Радецки“ 30, 5600 Троян
- 0670 62 022
- mbal_troyan@abv.bg
- ул. „Радецки“ 30, 5600 Троян

Диагностика и лечение на заболявания на сърдечно-съдовата, дихателната, храносмилателната и ендокринната системи.

Комплексни прегледи и проследяване на здравето на деца от раждането до юношеството.

Консултации и лечение при неврологични състояния като главоболие, световъртеж, инсулт, епилепсия и други.

Преданестезиологични консултации. Прегледи от опитни хирурзи, консултации преди и след оперативни интервенции. Диагностика и лечение на травми и заболявания.

Грижи се за безопасното протичане на упойката при операции и инвазивни процедури и за лечението на най-тежко болните пациенти в интензивна среда.

Грижа за женското здраве, проследяване на бременност, профилактика и лечение на гинекологични заболявания.

Изследвания на кръв и урина за диагностика на метаболитни, чернодробни и бъбречни заболявания.

Анализ на урина за наличие на инфекции, възпалителни и други заболявания.

Изследване на кръвни клетки – за анемии, възпалителни и хематологични заболявания.

Изследване на кръвосъсирване – важна част при предоперативни оценки и контрол на антикоагулантна терапия.

Допълнителни лабораторни тестове по преценка на специалист.
Изследвания за установяване на бактериални, вирусни и гъбични инфекции и определяне на антибиотична чувствителност.

В отделението се извършват съвременни изследвания чрез ултразвук, рентген и други методи за визуализация, подпомагащи бързата и точна диагностика.

Специализирано звено за микроскопско изследване на тъкани, подпомагащо откриването и класифицирането на заболявания.

Осигурява съвременно и комплексно лечение на пациенти с хронична бъбречна недостатъчност (ХБН) и други нефрологични заболявания.

Предлага комплексни програми за възстановяване чрез съвременни методи в специализирани зали.
МБАЛ Троян